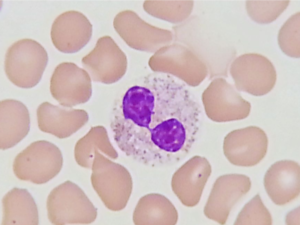
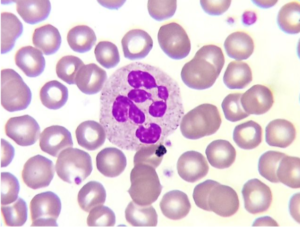

Ebook Digital
Atlas Básico de Hematología - Serie Blanca
"Domina la Serie Blanca: Tu guía esencial en Hematología".
- Con más de 28 páginas
- Más de 45 imágenes reales
- Realizado por profesionales

¿Por qué este Atlas es para mí?
- Si desconoces la bibliografía en donde consultar esta información.
- Si formas parte del mercado laboral o comienzas a estudiar el tema ahora.
- Si dispones de poco tiempo para estudiar.
¿Qué aprenderás?

Leucocitos normales:
- Neutrófilos
- Eosinófilos
- Basófilos
- Linfocitos
- Monocitos
Alteraciones en el núcleo de los leucocitos:
- Hiposegmentación de los neutrófilos
- Hipersegmentación
Alteraciones en el citoplasma de los leucocitos:
- Vacuolas en neutrófilos
- Cuerpos de Döhle
- Granulación azurófila (tóxica)
- Hipogranulación
- Linfocitos reactivos
¿Por qué invertir en un Ebook?
Acceso de por vida
Así es, es tuyo para siempre.
Economía
Un material digital es más económico que uno físico.
Agilidad
Puedes estudiar donde y como quieras.
Entrega Inmediata
Después del pago confirmado.
"Un Atlas, toda la Serie Blanca: Aprende, Identifica y Diagnostica."
Ebook Digital
Atlas Básico de Hematología - Serie Blanca
$200
Pesos mexicanos
Costo (pago unico)
- Con más de 28 páginas
- Más de 45 imágenes reales
- Realizado por profesionales
- Con temas relevantes
Descripción del Ebook
La serie blanca es clave en el diagnóstico de infecciones, enfermedades hematológicas y trastornos inmunológicos. Con el Atlas Básico de Hematología – Serie Blanca, tendrás en tus manos una herramienta visual imprescindible para identificar y comprender las alteraciones en leucocitos.
Este atlas ha sido diseñado especialmente para estudiantes, laboratoristas y profesionales del área clínica que buscan reforzar sus conocimientos y mejorar su capacidad diagnóstica. Incluye imágenes de alta calidad, descripciones detalladas y criterios claros para interpretar el frotis sanguíneo con precisión.
¡Haz de este atlas tu referencia indispensable y domina el arte del análisis hematológico!
Preguntas frecuentes
A continuación se muestran algunas dudas frecuentes, en caso de que su duda no se encuentre en la siguiente lista, nos puede contactar por correo o whatsapp.
Si usted tiene alguna dificultad, siga este paso a paso:
Si no pudo encontrar el correo electrónico en su bandeja de entrada, ¡no se preocupe! Simplemente, siga los pasos a continuación:
1.-Visite el enlace: https://purchase.hotmart.com
2.- En el campo “usuario o email”, ingrese su email
3.- En el campo Contraseña, ingrese su contraseña de Hotmart. Si no tiene una contraseña, simplemente haga clic en Olvidé mi contraseña.
4.- Finalmente, haga clic en «Entrar».
La liberación es inmediata DESPUÉS DE LA CONFIRMACIÓN DEL PAGO. Nota: la confirmación de las compras realizadas a través de tarjeta de crédito y PayPal son más rápidas que los pagos en efectivo (en este último caso el pago puede aprobarse en un lapso de 24 a 72 horas hábiles, por lo que el material se liberará en este tiempo).
No, usted está teniendo acceso a libros digitales cuyo propósito es prepararle más para la rutina de laboratorio.
¡No! Este material es para su uso exclusivo y personal. Por lo tanto, está prohibido compartir y/o comercializar los mismos, ya que es un delito previsto en el artículo 184 del código penal, con pena de 3 meses a 4 años de prisión o multa.
Aceptamos tarjeta de crédito, débito bancario, PayPal, saldo de Hotmart, entre otros.
Así es, es tuyo para siempre.